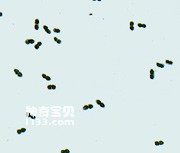
现代细菌的结构和生物学特征

时间:2025-06-21 17:05:10人气:0

时间:2025-06-21 17:05:05人气:0

时间:2025-06-21 17:05:04人气:0

时间:2025-06-21 17:05:04人气:0

时间:2025-06-21 17:04:58人气:0

时间:2025-06-21 17:04:57人气:0

时间:2025-06-21 17:04:57人气:0
时间:2025-06-21 17:04:52人气:0

时间:2025-06-21 17:04:50人气:0

时间:2025-06-21 17:04:49人气:0

时间:2025-06-21 17:04:44人气:0

时间:2025-06-21 17:04:43人气:0

时间:2025-06-21 17:04:43人气:0

时间:2025-06-21 17:04:42人气:0

时间:2025-06-21 17:04:36人气:0

时间:2025-06-21 17:04:36人气:0

时间:2025-06-21 17:04:35人气:0

时间:2025-06-21 17:04:29人气:0

时间:2025-06-21 17:04:28人气:0

时间:2025-06-21 17:04:23人气:0

时间:2025-06-21 17:04:22人气:0

时间:2025-06-21 17:04:18人气:0

时间:2025-06-21 17:04:16人气:0

时间:2025-06-21 17:04:12人气:0

时间:2025-06-21 17:04:11人气:0